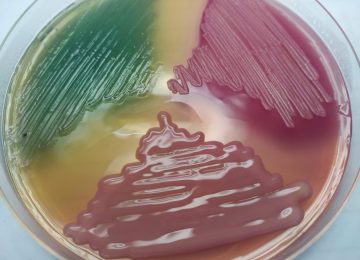
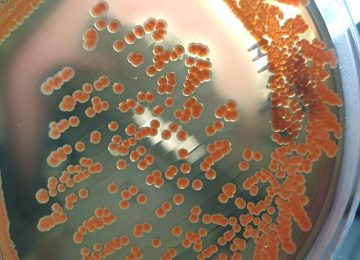

¿Qué aprenderás en este curso?
Competencia general de aprendizaje:
Competencia general de aprendizaje:
Evaluar críticamente y generar una predicción fundamentada de los perfiles de susceptibilidad a los antimicrobianos, mediante la aplicación y el manejo experto de los conocimientos sobre los patrones de resistencia intrínseca en bacilos Gram negativos y cocos Gram positivos de relevancia clínica.
Competencias específicas:
- Argumentar las ventajas derivadas de la aplicación del conocimiento sobre las resistencias bacterianas intrínsecas en el proceso de tamizaje y selección de terapia antimicrobiana.
- Comparar los principales mecanismos de la resistencia bacteriana naturales para comprender su impacto en el perfil de susceptibilidad a los antimicrobianos
- Representar y correlacionar la resistencia intrínseca específica en los grupos de Enterobacterales, identificando las implicaciones clínicas de estos patrones, para predecir la susceptibilidad antimicrobiana y orientar la selección terapéutica empírica inicial.
- Representar y correlacionar la resistencia intrínseca específica en bacilos Gram negativos no fermentadores, identificando las implicaciones clínicas de estos patrones, para predecir la susceptibilidad antimicrobiana y orientar la selección terapéutica empírica inicial.
- Representar y correlacionar la resistencia intrínseca específica en los Enterococos, identificando las implicaciones clínicas de estos patrones, para predecir la susceptibilidad antimicrobiana y orientar la selección terapéutica empírica inicial.
- Representar y correlacionar la resistencia intrínseca específica en los Estafilococos, identificando las implicaciones clínicas de estos patrones, para predecir la susceptibilidad antimicrobiana y orientar la selección terapéutica empírica inicial.
Duración: 10 semanas.
Carga horaria: 30 horas de estudio
Aula: guiasdemicro.com
- Atención personalizada
- Casos de estudio
- Actividades interactivas
- Bibliografía científica
- Foros de discusión
- Flexibilidad de aprendizaje
- Aula disponible 24/7
- Experiencias significativas
Facilitadora
Lcda. Carolina Macero.
Esp. en Bacteriología clínica.
MÓDULO 1
Introducción al programa académico y funcionamiento del aula virtual.
Unidad 1. Generalidades del perfil de resistencia bacteriana.
Unidad 2. Tipos de mecanismos de resistencia bacteriana intrínseca.
Actividades propuestas en aula:
Foro de presentación.
Foro de discusión.
Materiales: 6 videos, 5 lecturas, ejemplos de manejo del aula y ejercicios de autoevaluación.
Tiempo sugerido: 5 horas para completar
MÓDULO 2
Unidad 3. Resistencia intrínseca en Enterobacterales.
Actividades propuestas en aula:
Foro de discusión.
Materiales: 5 videos, 3 lecturas y ejercicios de autoevaluación.
Tiempo sugerido: 5 horas para completar
MÓDULO 3
Unidad 4. Resistencia intrínseca en Bacilos Gram negativos no fermentadores.
Actividades propuestas en aula:
Foro de discusión.
Materiales: 3 videos, 3 lecturas y ejercicios de autoevaluación.
Tiempo sugerido: 5 horas para completar
MÓDULO 4
Unidad 5. Resistencia intrínseca en Enterococos
Actividades propuestas en aula:
Foro de discusión.
Materiales: 2 videos, 2 lecturas y ejercicios de autoevaluación.
Tiempo sugerido: 4 horas para completar
MÓDULO 5
Unidad 6. Resistencia intrínseca en Estafilococos.
Actividades propuestas en aula:
Foro de discusión.
Materiales: 3 videos, 2 lecturas y ejercicios de autoevaluación.
Tiempo sugerido: 3 horas para completar
MÓDULO 6
Ejercicios de consolidación mediante resolución de casos clínicos.
Actividades propuestas en aula:
Foro de discusión.
Materiales: 6 casos clínicos
Tiempo sugerido: 4 horas para completar
MÓDULO 7
Repaso.
Actividades propuestas en aula:
Ejercicios de revisión
Foro de repaso
Tiempo sugerido: 3 horas para completar
MÓDULO 8
Prueba final.
Actividades propuestas en aula:
Evaluación final, foro de finalización y encuesta.
Entrega de certificados.
CONOCER LA RESISTENCIA ANTIMICROBIANA INTRÍNSECA: EL PRIMER PASO PARA EL USO RACIONAL DE LOS ANTIBIÓTICOS.
 La resistencia intrínseca, describe mecanismos de evasión natural de la actividad antibacteriana en varias familias de microorganismos saprofitos y patógenos. Se considera que el origen evolutivo de dicha resistencia viene de la necesidad de supervivencia en ambientes de alta densidad bacteriana, principalmente para la obtención de nutrientes y la defensa frente a bacterias predadoras. La mayor parte del tiempo, estos mecanismos se expresan de forma constitutiva (Ej. resistencia a ampicilina en K.pneumoniae complex). Sin embargo, en ambientes de baja presión antibiótica, o debido a las variaciones en las pruebas de susceptibilidad (efecto inóculo), esta resistencia puede no evidenciarse; pero el mecanismo no desaparece y puede expresarse en el curso de una terapia inadecuada.
La resistencia intrínseca, describe mecanismos de evasión natural de la actividad antibacteriana en varias familias de microorganismos saprofitos y patógenos. Se considera que el origen evolutivo de dicha resistencia viene de la necesidad de supervivencia en ambientes de alta densidad bacteriana, principalmente para la obtención de nutrientes y la defensa frente a bacterias predadoras. La mayor parte del tiempo, estos mecanismos se expresan de forma constitutiva (Ej. resistencia a ampicilina en K.pneumoniae complex). Sin embargo, en ambientes de baja presión antibiótica, o debido a las variaciones en las pruebas de susceptibilidad (efecto inóculo), esta resistencia puede no evidenciarse; pero el mecanismo no desaparece y puede expresarse en el curso de una terapia inadecuada.
¿Por qué conocer la resistencia intrínseca es importante para la práctica clínica?
Conocer la resistencia natural de las especies bacterianas más frecuentes en la práctica clínica es la primera aproximación al uso prudente de antibióticos, y debe ser una piedra angular de todo programa de optimización de antimicrobianos (PROA). La adquisición de este conocimiento permite:
- Disminuir la probabilidad de falla terapéutica: Utilizar antibióticos para los cuales la bacteria está capacitada con un mecanismo para evadir su acción, expondría al paciente a una terapia inapropiada/ inefectiva, que compromete su seguridad y que impactaría en un exceso de morbi/mortalidad.
- Disminuir la presión selectiva: Los antibióticos para los cuales una especie bacteriana expresa mecanismos intrínsecos de resistencia, terminarían seleccionando su presencia en la microbiota normal del paciente, al eliminar otras especies susceptibles y permitir su supervivencia.
- Disminuir los costos asociados a la atención: El uso de antibióticos con resistencia intrínseca, llevaría a falla terapéutica o respuesta tardía, que terminaría en un cambio de antibiótico, mayores tiempos de estancia, gastos mayores en otras pruebas de laboratorio y procedimientos médicos.
- Optimizar el tamizaje de antibióticos más efectivos: Antibióticos con resistencia natural, no deben ser tamizados; y si son tamizados deben ser siempre informados como resistentes. Este conocimiento permitiría tamizar moléculas más eficaces, que se asocien con mejor desenlace clínico y disminución de los costos y estabilización o reducción de la resistencia antimicrobiana.
Entonces, el conocimiento de la resistencia antimicrobiana intrínseca, es un componente básico del entrenamiento necesario en microbiólogos, bioanalistas y médicos para un tamizaje y uso apropiado de los antibióticos a nivel hospitalario.
Bienvenidos a GUIAS DE MICRO.
GERMAN ESPARZA
Director del programa de Proeficiencia en Microbiología PROASECAL
Profesor de Microbiología de la Pontificia Universidad Javeriana
Profesor de microbiología- Universidad del Rosario
Coordinador del Comité de Microbiología de la Asociación Panamericana de Infectología API.
Miembro del panel de expertos en microbiología del CLSI de Estados Unidos.
Me complace aceptar la amable invitación de la destacada microbióloga Carolina Macero, de hacer una pequeña introducción a su primer curso online sobre Resistencia Bacteriana.
Conozco y admiro el trabajo de Carolina y le deseo mucho éxito en este nuevo proyecto.
Las bacterias, presentes por milenios, muchas veces “nacen aprendidas” y son capaces de resistir los distintos elementos del ambiente capaces de destruirlas. En el campo estrictamente de bacterias capaces de causar infecciones en los humanos y en los animales, esta “resistencia intrínseca”, las capacita para resistir a sus hoy mayores enemigos, los antibióticos. Es importante tomar en cuenta que, al utilizar antibióticos de amplio espectro, como por ejemplo los carbapenémicos, aquellas bacterias naturalmente resistentes, como por ejemplo la Stenotrophomonas maltophilia, tenderá a aparecer y sobreponerse a otras especies.
 Es cierto que los mecanismos trasmisibles de resistencia (plásmidos, transposones) son responsables de la mayor frecuencia de resistencia, y son portadores de la información que permite producir muchas de las enzimas (BLEE, Carbapenemasas, enzimas modificadoras de aminoglucósidos o quinolonas) que causan resistencia a antibióticos de uso común. Pero conocer que un bueno número de microorganimos ya vienen con su resistencia innata, es fundamental para tener un conocimiento más amplio de la magnitud del problema.
Es cierto que los mecanismos trasmisibles de resistencia (plásmidos, transposones) son responsables de la mayor frecuencia de resistencia, y son portadores de la información que permite producir muchas de las enzimas (BLEE, Carbapenemasas, enzimas modificadoras de aminoglucósidos o quinolonas) que causan resistencia a antibióticos de uso común. Pero conocer que un bueno número de microorganimos ya vienen con su resistencia innata, es fundamental para tener un conocimiento más amplio de la magnitud del problema.
Utilizar aminoglucósidos como droga única en las infecciones por Enterococo resultaría en falla, por ser estos organismos naturalmente resistentes. Esa resistencia intrínseca se puede moderar al combinar con un agente activo contra la pared bacteriana (B-láctámicos o vancomicina, por ejemplo) ColistÍn es considerado hoy uno de los últimos recursos en el tratamiento de infecciones por Enterobacterias multirresistentes. Sin embargo, Serratia, por ejemplo, es naturalmente resistente.
Estoy seguro que este curso que ahora está en sus manos le permitirá comprender mejor el apasionante mundo de la resistencia bacteriana a los antibióticos.
¡Gracias a Carolina por hacerlo posible!
Dr. Manuel Guzmán Blanco
Médico Infectólogo del Centro Médico de Caracas.
Jefe del Servicio de Infectología del Hospital Vargas
Coordinador Nacional del Programa Venezolano de Vigilancia de la Resistencia Bacteriana a los Antimicrobianos (PROVENRA)
«Para la adecuada toma de decisiones en el tratamiento de pacientes con infección bacteriana es muy importante la identificación del microorganismo patógeno involucrado y su patrón de sensibilidad. El conocimento de la resistencia intrínseca, con el adecuado análisis de los resultados del antibiograma permite optimizar la terapia antibacteriana dirigida. La información microbiológica específica en cada paciente constituye una herramienta relevante para la práctica médica de calidad».

Dra. Luigina Siciliano Sabatela
Infectólogo Pediatra. Jefe del Servicio de Infectología. Hospital de Niños «J.M. de los Ríos».
Directora del postgrado de Infectología Pediátrica con sede en el mismo servicio del Hospital.
Profesora asociada. Cátedra de Pediatría- Escuela de Medicina «J.M.Vargas». Universidad Central de Venezuela.


«Las bacterias hablan silenciosamente con sus características propias de los mecanismos de resistencia intrínseca. Conocer esos mecanismos de resistencia nos ayuda a confirmar especies y a detectar falsos reportes de antibiogramas que nos deben poner alertas, ante el posible fracaso terapéutico de sustancias que no son activas in vivo».

Dra. Lorena Abadía
Investigador
Docente de la Universidad de Oriente- Venezuela
Coordinadora del Laboratorio de Resistencia Bacteriana del Instituto de Investigaciones en Biomedicina y Ciencias Aplicadas de la Universidad de Oriente – Venezuela.
IG: @biocienciaabadia
«Las bacterias son más antiguas que el ser humano y han logrado llegar hasta nuestros días a través del desarrollo de diversos mecanismos de resistencia. La resistencia adquirida, viene dada por la exposición previa de las bacterias a los antibióticos o por la transmisión de genes que les confieren resistencia; y, por otro lado, la resistencia intrínseca es una característica natural que las hace insensibles a determinados antibióticos. Al momento de indicar un esquema de antibiótico, empírico o con cultivo disponible, es de vital importancia tener presente esta característica, a fin de evitar hacer mal uso de los mismos, lo cual se traduce no sólo en el aumento de la resistencia bacteriana, sino en falla clínica que puede poner en riesgo de la vida del paciente».

Dr. Héctor Villaroel
Médico Infectólogo – Centro Médico de Caracas y Hospital Dr. Miguel Pérez Carreño
IG:@drhectorvp


